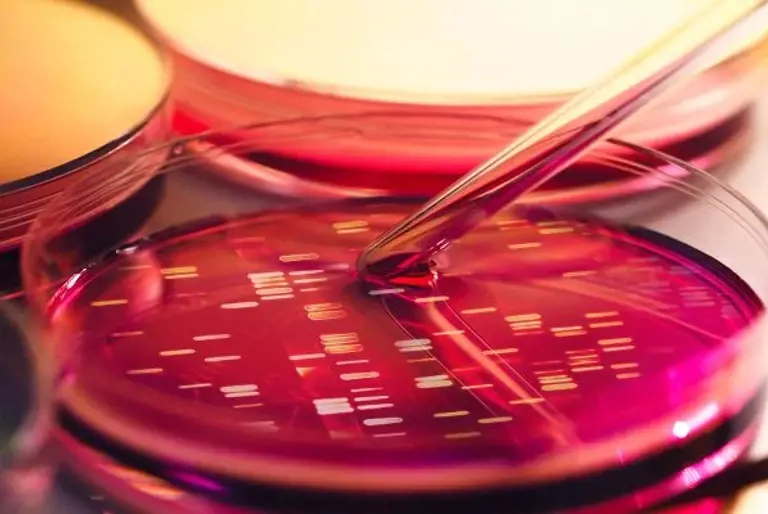

The Life Sciences group at Franks & Co. handles subject matter which ranges from bio-chemistry, biology and bio-technology through to medical devices, nano-technology, pharma-technology and medicine as well as food science.

The group delivers strong intellectual property protection for our client’s technological advances in biomedical life sciences, which is a fast growing area of research and technology.
At Franks & Co, a number of our technical staff have extensive experience in handling scientific subject matter in the field of life sciences acting for a broad range of innovative clients including Universities, SME’s and large multinationals.
The Life Sciences group continually aim to advise and tailor such advice to offer the most advantageous commercial strategy for the client. This can be through dedicated client case management leading to local or global patent protection and enforcement.
Experts in Life Sciences